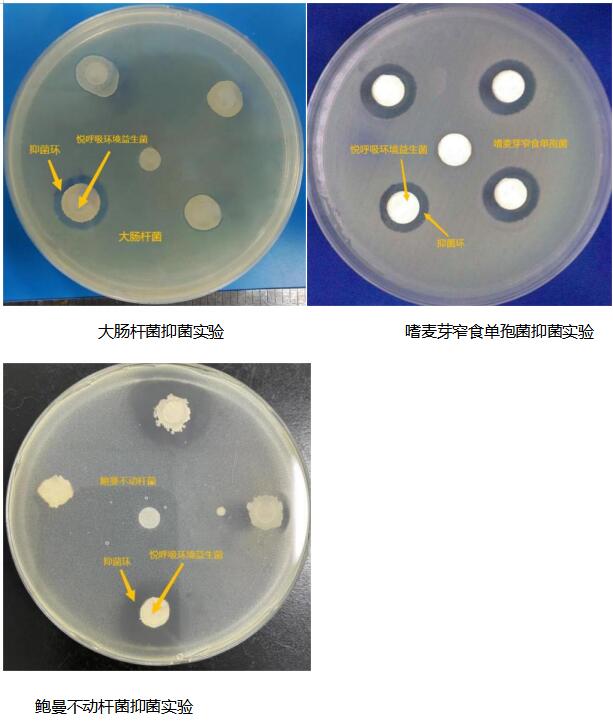

悦呼吸环境益生菌是由多种类型的芽孢杆菌,以一定的比例混合制成的液体制剂。其使用的芽孢杆菌是悦呼吸研发团队从神农架的土壤中,筛选出的具有极强的抗逆性的天然益生菌。
悦呼吸环境益生菌的功能在于净化和改善家居环境,从而营造一个安全健康的生活条件。益生菌能够从根源去除室内的污染源,包括细菌、病毒、花粉过敏原、螨虫过敏原、宠物过敏原、尼古丁、甲醛之类的有机或无机污染源等,目前这些数据均有第三方权威机构的检测报告。
为了进一步研究悦呼吸环境益生菌对常见致病菌的抑制效果,悦呼吸研发团队重新进行了抑菌实验,对嗜麦芽窄食单孢菌、鲍曼不动杆菌等条件致病菌进行了探究。
结果表明悦呼吸环境益生菌确实能够抑制大肠杆菌、嗜麦芽窄食单孢菌、鲍曼不动杆菌这些条件致病菌的生长,并能产生明显的抑菌环,如图所示。
什么是抑菌环呢?
简单来说,抑菌环的产生是由于益生菌在生长过程中会分泌抑菌物质,它能够使其周围的细菌生长受到抑制从而形成透明圈,即抑菌环,根据抑菌环大小可以判定待测益生菌对该菌的抑制效果。抑菌环越大,说明益生菌的抑菌效果越强。悦呼吸环境益生菌的抑菌环显著,对各类致病菌的抑制作用强大。
悦呼吸环境益生菌对霉菌也有着抑制作用。在以下实验结果图中可以明显看出,悦呼吸环境益生菌有效抑制并阻断了霉菌的进一步生长和繁殖。
悦呼吸环境益生菌对霉菌有抑菌作用
悦呼吸环境益生菌还能抑制真菌孢子的萌发。在以下对照实验中可以看出没有添加悦呼吸环境益生菌的真菌孢子已完全萌发,使用了悦呼吸环境益生菌样本中的真菌孢子没有萌发,实验证明,悦呼吸环境益生菌液可以通过抑制环境中霉菌孢子萌发,达到抑制霉菌生长繁殖的目的,坚持使用悦呼吸环境益生菌,可以大大降低室内霉菌的比例。 
悦呼吸环境益生菌抑制真菌孢子萌发
悦呼吸环境益生菌能对上述的致病菌产生抑制作用,主要的原理是益生菌的三个抑菌机制。悦呼吸环境益生菌通过产生小分子抑菌化合物,抑制其致病菌萌发。还能够与其他病原微生物竞争营养物质和生存空间,进一步有效减少室内环境中致病菌的数量跟占比,为人们创造一个更健康、更舒适的生活环境。

对于那些容易受到致病菌影响的人群,如老年人、儿童、孕妇和免疫力低下人来说,使用悦呼吸环境益生菌也是一种有效的预防措施。悦呼吸的4款产品,均添加了悦呼吸环境益生菌。
1智能微生物全净器
全屋无盲区净化。一台全净器=空气净化器+除味剂+消毒剂+除螨仪

2益生菌便携净化器
轻巧便携,随处可放,三档调节,不占空间

3益生菌深层净化喷雾
出入人群密集场所,随时随地喷一喷,即刻防护

4 悦呼吸环境益生菌7天装
放入到分装喷雾瓶或加湿器中,方便快捷,极速净化

悦呼吸环境益生菌用于室内净化,是一种天然、环保的方法,对人体无害,对环境友好。
上述所有实验中,悦呼吸环境益生菌展现强大的抑菌能力,无疑是室内环境的守护者。